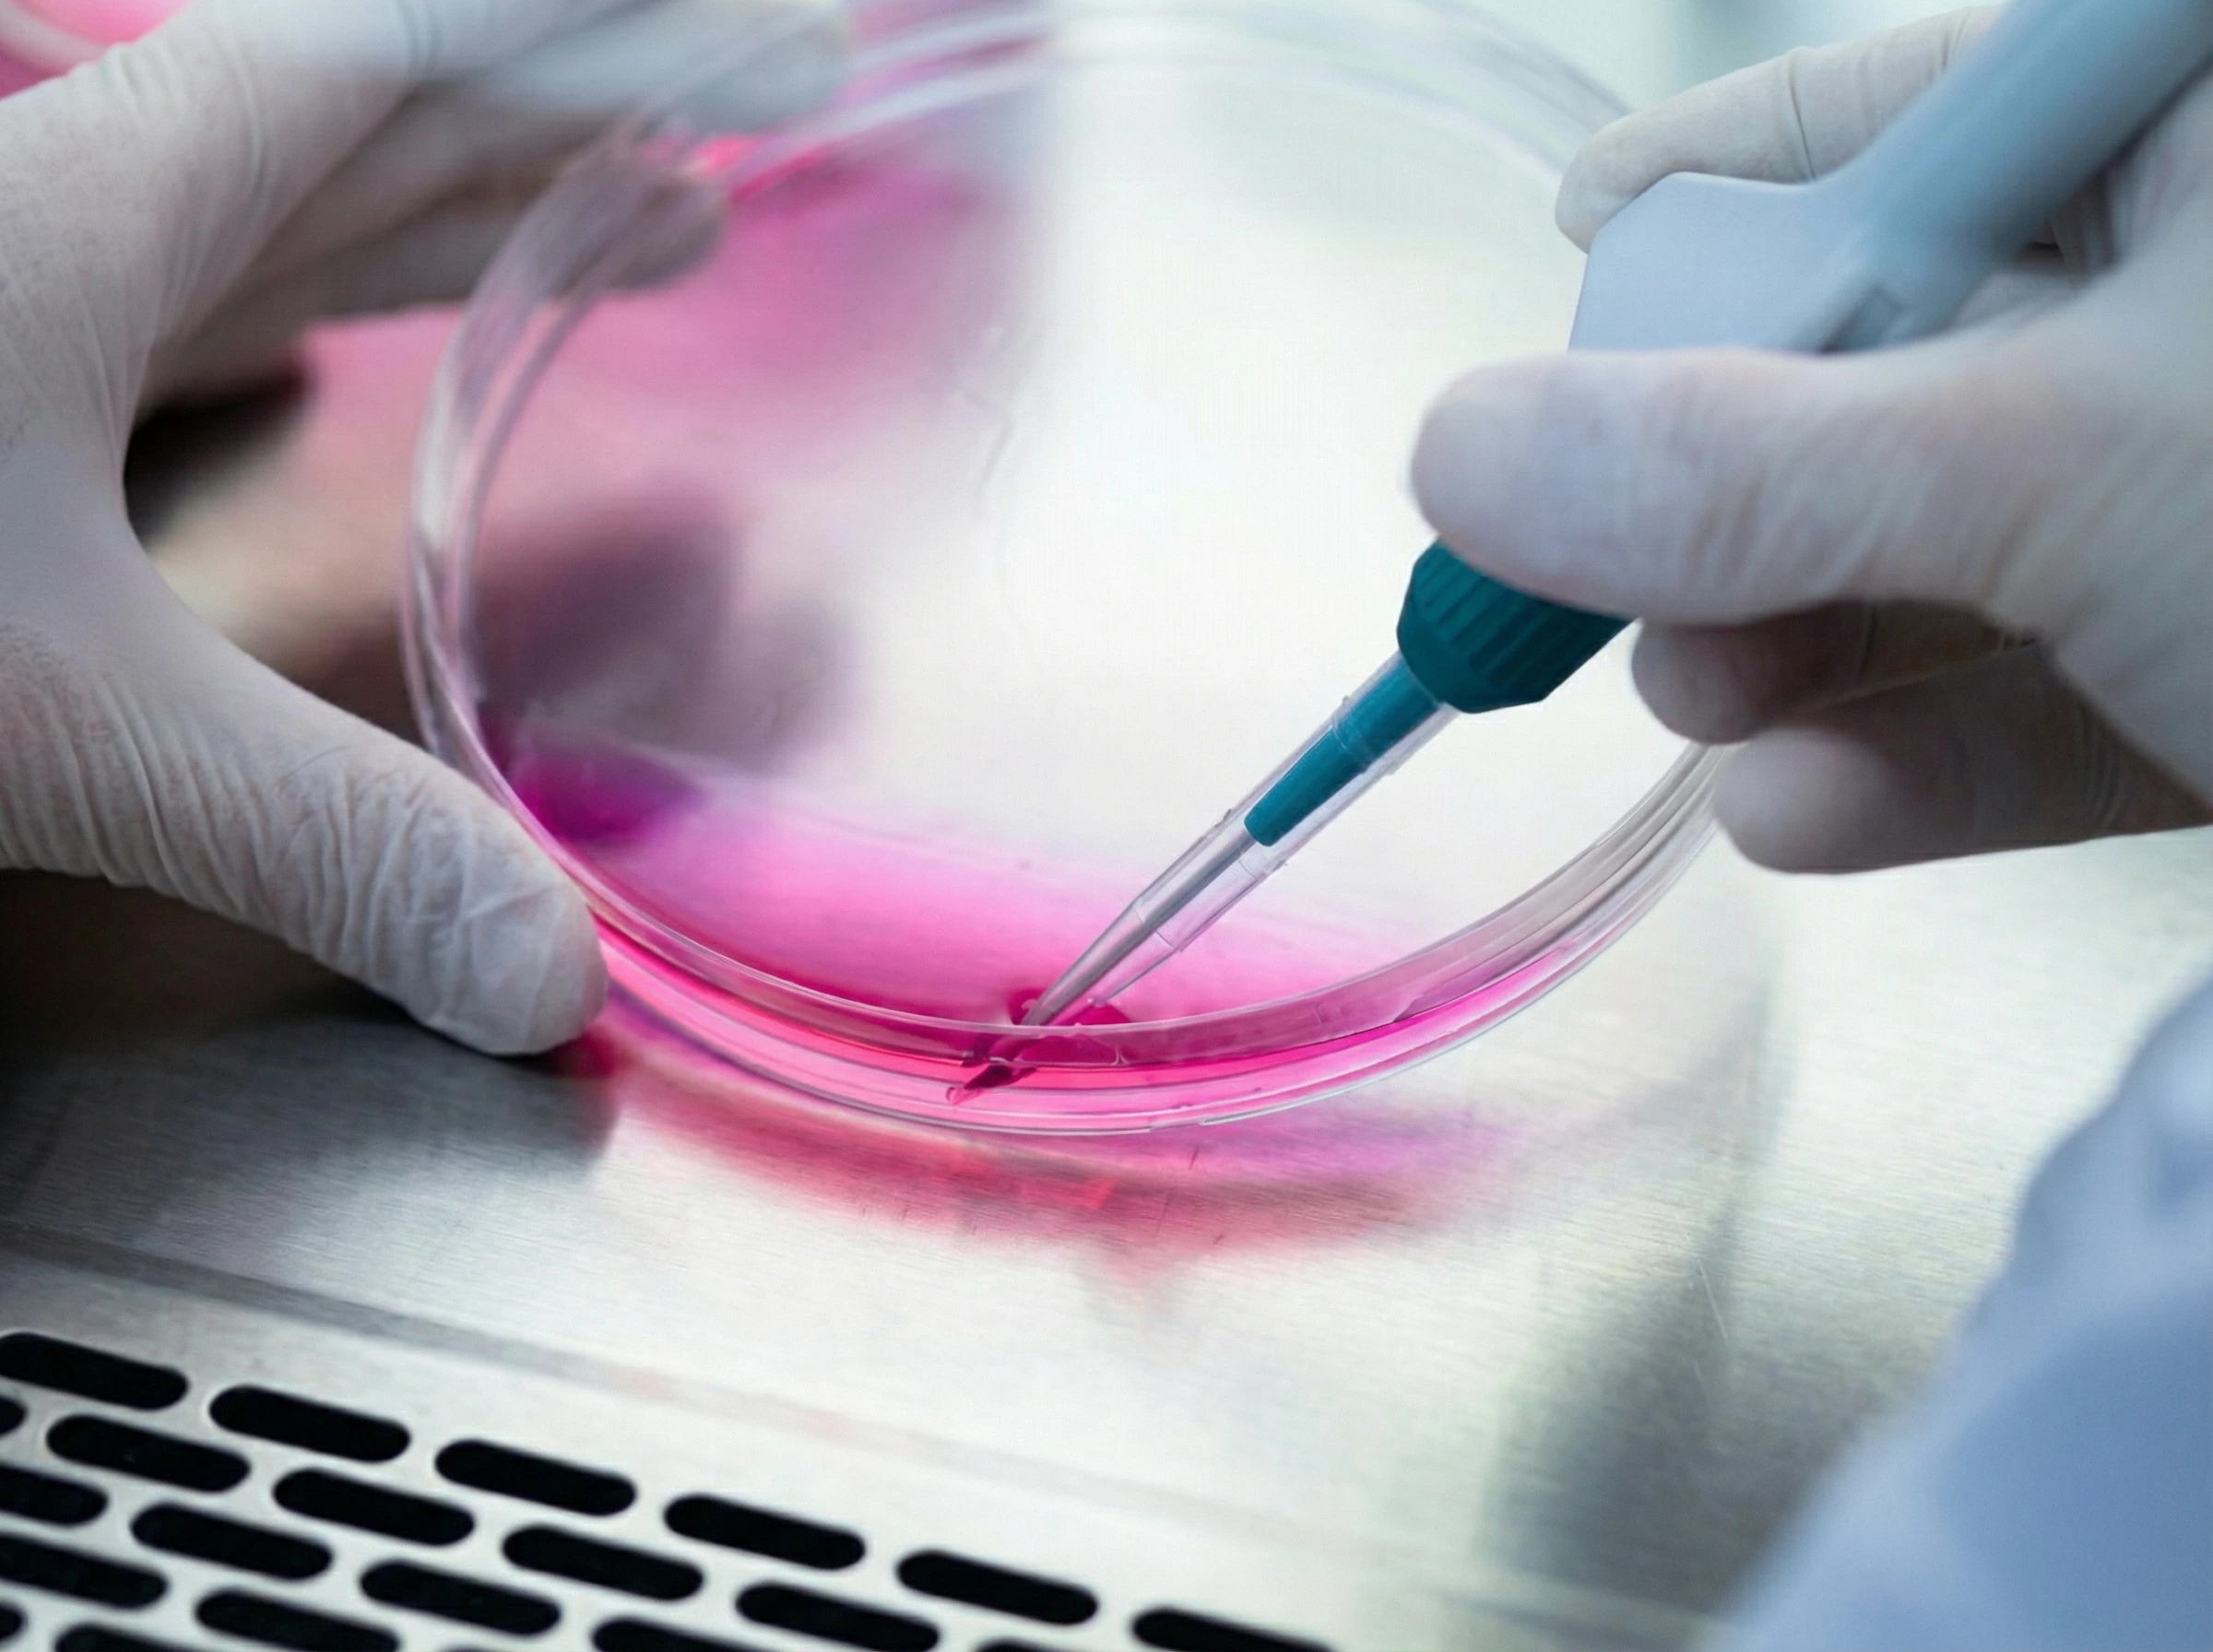
Laboratory technician using a micropipette on a petri dish during stem cell preparation

MSC Therapy
At NM Stem Cell, we are dedicated to pioneering the integration of regenerative medicine and advanced technology. Among our innovative treatments is MSC therapy, a regenerative method that capitalizes on the unique properties of mesenchymal stem cells (MSCs).
Learn About MSC Therapy
Wharton's Jelly Mesenchymal Stem Cells (WJ-MSCs)
Wharton's Jelly Mesenchymal Stem Cells (WJ-MSCs) are a specific type of stem cell found within the umbilical cord. To understand them, it helps to break down the name:
Wharton's Jelly: This is the gelatinous, cushion-like substance inside the umbilical cord. Its natural job is to protect and insulate the blood vessels that carry nutrients between a mother and her baby.
Mesenchymal Stem Cells (MSCs): These are "master cells" that act like the body's repair kit. They have the unique ability to calm inflammation and signal other cells to start repairing damaged tissue.
These cells are not fetal cells. They are ethically sourced from donated umbilical cords after healthy births and work by stimulating your body's own cell growth and repair processes.
Where do they come from?
These cells are harvested from healthy, full-term umbilical cords donated by mothers after a C-section birth. Because the umbilical cord is typically discarded as medical waste after a baby is born, harvesting these cells is non-invasive and ethically non-controversial compared to other types of stem cells.
How do they work?
Think of these cells not as "building blocks" that turn into new tissue themselves, but rather as dispatchers. When introduced to an injured area, they release a "secretome" -- a cocktail of growth factors and proteins -- that gives instructions to your body's existing cells to:
Reduce Inflammation
They can calm down an overactive immune response.
Stimulate Repair
They encourage the growth of new blood vessels and tissue regeneration.
Reduce Scarring
They may help tissues heal with less fibrosis (scar tissue).
Common conditions being researched
While many potential uses are still in clinical trials, doctors are investigating WJ-MSCs for:
Rigorously processed in certified laboratories
Every MSC treatment uses Wharton's Jelly MSCs that are carefully harvested, tested, and prepared under strict quality controls to ensure safety and potency.

Why Wharton's Jelly MSCs?
Wharton's Jelly is a rich source of young, vibrant MSCs that can stimulate tissue growth, repair, and regeneration more effectively than other sources. Because these cells come from donated umbilical cords after healthy births, they are ethically sourced and carry minimal risk of rejection.
When introduced to an injured area, WJ-MSCs release a powerful cocktail of growth factors and proteins -- the "secretome" -- that instructs your body's existing cells to reduce inflammation, grow new blood vessels, regenerate tissue, and heal with less scarring.
Conditions We Treat
Joint Conditions
Soft Tissue Injuries
Spinal Conditions
Other Conditions

Get Back to the Life You Love
Our patients don't just find relief from pain -- they rediscover the activities that bring them joy. Whether it's returning to the gym, playing with grandchildren, or simply moving without limitation, MSC therapy helps restore the freedom that chronic pain takes away.
MSC Therapy: An Alternative to Joint Replacement Surgery
MSC therapy has gained recognition as an excellent alternative to joint replacement surgery and here's why:
Minimally Invasive
Unlike joint replacement surgery, MSC therapy is minimally invasive. It involves injecting MSCs directly into the affected area, thereby bypassing the risks associated with major surgeries.
Natural Healing
MSC therapy encourages the body's healing processes. Rather than replacing the joint with an artificial one, MSCs rejuvenate and repair the damaged tissues from within, often resulting in a more natural feel and function.
Faster Recovery
Patients undergoing MSC therapy generally experience quicker recovery times compared to those who opt for joint replacement surgery. This faster return to normal activities reduces the emotional and financial burden associated with long-term recovery.
Future Treatment Options Remain Open
Even after undergoing MSC therapy, surgical interventions remain a viable option, if required. This approach ensures that patients have the flexibility to explore other treatment options later.
Reduced Risk of Rejection
With joint replacements, there's a risk of the body rejecting the artificial joint. However, since MSCs are biocompatible and immunomodulatory, they have a lower chance of provoking a harmful immune response.
Effective Pain Management
MSC therapy goes beyond just treating symptoms. By healing damaged tissues and reducing inflammation, it offers long-term pain relief, reducing reliance on pain medications.
Frequently Asked Questions

Rediscover the freedom of pain-free movement
From hiking trails to everyday activities, MSC therapy patients are getting back to the life they love.
Discover a Healthier, More Vibrant You
At NM Stem Cell, we're committed to utilizing regenerative medicine's potential to offer innovative solutions for health and wellness. Our MSC therapy is designed to enhance your body's natural healing abilities and improve your quality of life.
